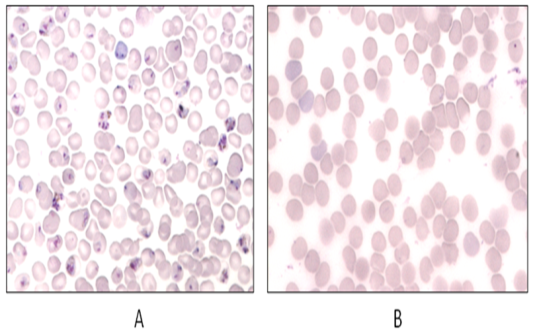

1Department of Pharmacology and Toxicology, 2Department of Pharmaceutical Technology (Formulations) NIPER, S. A. S. Nagar, Mohali, Punjab 160062 Email: c.singhniper09@gmail.com
Received: 16 Jul 2014 Revised and Accepted: 22 Aug 2014
Objective: Malaria is the deadliest infectious diseases affecting millions of people worldwide. Several strategies have been under extensive research since decades including chemoprophylaxis and other disease antimalarial interventions like malaria vaccine. The vaccine development is more difficult to predict than drug development and presents a unique challenge as already there has been no vaccine effective against a parasite. For development and screening of malaria vaccine, a suitable animal model is the prime requirement. Non-human primate models are considerably a good choice to mimic human malarias, but due to various reasons like ethical, cost effective, maintenance and relative ease of conducting experiments. Rodent’s malaria vaccination models remain the preferred choice.
Methods: To develop such model we required 100% lethal host/parasite system that would be an ideal system for experimental vaccination studies. Such a rigorous model is particularly required for the identification and development of suitable adjuvant/co-adjuvant(s) for future human malaria vaccines.
Results: Because, P. yoelii nigeriensis invariably causes a 100% lethal fulminating infection in Swiss mice, so in present studies, we vaccinate Swiss mice with P. yoelii nigeriensis total P. yoelii nigeriensis - Soluble antigen (Pyn-SA)and saponin as adjuvant, following 100% lethal study homologous challenge and then followed by passive transfer of experiment.
Conclusion: P. yoelii nigeriensis caused a fulminant 100% lethal infection in mice (as saw in the control groups). The protection observed in the vaccinated group of mice can be unambiguously ascribed to vaccine-induced protective immunity only.
Keywords: Malaria, Vaccine, Pre-erythrocytic (PE),Blood-stage (BS), Circumsporozoite protein (CSP), Merozoite surface protein (MSP).
Malaria is one of the greatest burdens to mankind, with a mortality rate that is unrivaled by any other modern disease unlike tuberculosis [1]. This incapacitating disease is caused by four different agents (Plasmodium falciparum, Plasmodium vivax, Plasmodium malariae and Plasmodium ovale) of the same genus [2]. Malaria remains one of the leading causes of morbidity and mortality in the tropics. Malaria affects more than 2400 million people; about 40% of the global population is at a risk of malaria. In some countries with a heavy malaria burden, the disease may account for as much as 40% of public health expenditure, 30-50% of in-patient admissions, and up to 50% of out-patient visits. It has been estimated that there were about 207 million cases of malaria in 2012 and an estimated 627, 000 deaths [3, 4].
Several strategies have been tested to combat this disease and innumerable attempts have been made to launch a malaria vaccine. Despite several efforts in the past five decades, we do not have a clinically accepted malaria vaccine. Safety, efficacy, cost and provision of the vaccine to all communities are major concerns in malaria vaccine issue [5,6]. Some of the difficulties encountered in malaria vaccine research are, parasite induced immunosuppression, intracellular parasites, mutation of parasites, multiple antigens (specific to species and stage), antigenic variations, lack of suitable animal models for malaria vaccination studies, lack of effective and safe adjuvant/co-adjuvant, and that of suitable animal models to identify, evaluate and develop them, lack of the availability of in-vitro assays that can predict protective immunity in-vivo and lack of detailed knowledge of the mechanisms of pathogenesis and protective immunity in malaria [7].
Naturally acquired immunity to malaria is slow to develop, non-sterilizing and short-lived in the absence of continuous exposure. The parasite rapidly develops resistance to anti-malarial drugs and treatment is often followed by reinfection. Hence, there is an urgent need to develop a malaria vaccine [8].
Preclinical vaccination studies have been tried in primate; avians and rodent models [9]. Rodent malaria causing parasites provide an available model for understanding the mechanisms of human Plasmodium infections [10]. Studies involving the mouse model of blood stage malaria infections have demonstrated that CD4+ Th1 and Th2 cells are essential for the control of primary parasitemia and specific antibodies are responsible for the clearance of malaria-causing parasites thereafter. Immunity against severe malaria may also depend upon the host's ability to fine tune the magnitude and process of the cellular immune response, which allows appropriate production and timing of inflammatory or anti-inflammatory cytokines at key stages of the infection [11,12]. Many rodent malaria models have been identified, developed and studied. Out of these, the most widely used as experimental vaccination models are P. yoelii 17X, P. yoelii (YM strain), and P. berghei infection in various types of mice [13]. Using the rodent models, a diverse group of adjuvants like saponin, aluminium hydroxide, non-ionic block polymers, copolymer P1004, IFN-α, and detoxified lipopolysaccharide as well as bacteria including Bordetella pertussis, Corynebacterium parvum and Salmonella typhimurium have been evaluated [14]. Protective immunity to the asexual blood forms of malaria parasites, the pathogenic stage of the life cycle, involves both cellular and antibody mediated mechanisms [15].
Adjuvants are substances (e. g. Minerals salts, oil emulsions, bacterial products, saponins) which upon administration lead to non-specific immune stimulation. When the adjuvants is used in a vaccine, the goal is to induce immune response and memory sufficient to protect against a harmful organism while for the production of antibodies the main goal is to elicit the highest specific antibody response achievable [14]. The acceptability of side effects is determined by the species in which the adjuvant is applied [16].
With aforementioned background, we had proposed the following hypothesis that is to experimentally immunize mice using Pyn-soluble antigens. In this study, we develop this host/parasite system into a rigorous rodent malaria vaccination model to study the new dimensions of immune protection.
MATERIALS AND METHODS
Animals
Swiss mice (Mus musculus), male, weighing 20–22 g, supplied by the Central Animal Facility. NIPER, were used in all the experiments. Animals were kept in temperature (22–24°C) and light (12 h on/off) controlled rooms and provided with standard animal feed and clean water (with 0.005% PABA) ad libitum. All experiments were carried out in accordance with the Guidelines for Care and Use of Animals in Scientific Research, Indian National Science Academy, New Delhi, India, as adopted and promulgated by the Institutional Animal Ethics Committee.
ParasitesPyn-MDR has been used for the preparation of vaccine and for infecting the mice. The strain has been maintained in Swiss mice by serial passage. The strain shows a high level of virulence and produces 100% lethal infection. The parasite strain was maintained, separately, by serial infected-blood-passage in mice and cryopreservation.
ReagentsSaponin, used as an adjuvant for the vaccine was from HIMEDIA. Histopaque-1077 from Sigma Aldrich. Bio-Rad’s Bradford kit and Bradford method were used for estimating the protein content in the crude antigen preparation. The reagents used were bovine serum albumin (BSA), concentrating dye reagent, Wright’s stain (HIMEDIA), ethanol (Sigma Aldrich), isopropyl alcohol, DMEM (PAA), disodium hydrogen phosphate (Merck India Ltd., Mumbai, India; 9.5 g) and potassium dihydrogen phosphate (Merck; 9.06 g) for preparing the staining buffer and 3.2% w/v sodium citrate saline solution as the anti-coagulant [17].
Initiation of infectionFor initiation of infection, mice were infected i.p. with a counted inoculums of 1x107 infected erythrocytes (IE), obtained by cardiac puncture from a previously infected donor mouse. Infection was maintained by serial blood passage.
Enumeration of parasitemiaBrief procedure for the enumeration of parasitemia is as follows. A thin blood smear made from a small drop of cut tail-blood of a mouse was air-dried. The smear was then covered with Wright’s stain. After about 4–5 min it was covered with staining buffer for 12 min. It was then washed with more staining buffer and air dried. The slides were monitored under oil immersion lens of a light microscope (Model no. Eclipse E-600, Nikon, Japan). The parasitemia was expressed as % IE after microscopic examination of 1 x 104 erythrocytes.
Preparation of antigenIn most of the vaccination studies, the soluble material, which is a small representative subset of the total parasite antigens, was found as potent immunogen as the intact IE [18]. Brief procedure of antigen preparation is as follows. First, 2 donor mice were prepared by injecting with a counted inoculums of 1 x 106 IE. On day 4, the mouse with 2–5% parasitemia was used to infect a batch of 15 healthy mice conditioned with 12 h light-dark cycle. Briefly [18], when donor mice had > 80 % parasitemia, the maximum number of schizonts, they were bled in pre-chilled citrate saline. The blood-citrate mixture was then kept overnight at 4°C which results in the formation of different layers and infected erythrocytes and normal erythrocytes layers become visible. Upper infected erythrocytes layer (schizonts rich layer) was aspirated using a sterile Pasteur pipette in a sterile centrifuge tube and centrifuged at 3000 g for 15 min at 4°C. They were washed thrice with chilled DMEM. Smear slides were prepared and parasitemia was checked. When 90% schizonts and very few rings were seen, the pelleted IEs were lysed by the rapid cycle of freezing and thawing. Figure 1 clearly shows the lysis of IEs (arrow marked). The crude cell lysate was centrifuged, and clear supernatant was decanted. Protein estimation for this supernatant was done using the Bradford method (Biorad Protein Estimation Kit) and its concentration was adjusted to 2.1 mg/ml. The antigen-based vaccine was stored as aliquots of 100 µl at -70°C. The same antigen preparation was used in all the experiments. And similarly NEA was prepared using blood of normal mice.

Fig. 1: Cell lysis showing ruptured RBCs
Protein estimationThe Bio-Rad Protein Assay, based on the method of Bradford, is a simple and accurate procedure for determining concentration of solubilized protein. It involves the addition of an acidic dye to protein solution, and subsequent measurement at 595 nm with spectrophotometer or microplate reader. Comparison to a standard curve provides a relative measurement of protein concentration [19].
Vaccine formulationAfter preparation of antigens, vaccine is prepared by mixing antigen and adjuvant using double locking hub connector. Mixing was done at 4°C in sterile conditions at the time of dosing or immunization. For this antigens is taken in one syringe and adjuvant in another syringe and by the help of piston two were mixed thoroughly until an emulsion is formed [20].
Immunization and challengeThe antigen aliquots were prepared into solutions along with saponin as the adjuvant in the same concentration as the antigen. The mixing was done at 4°C. The doses were then administered s. c. or i. p., on days 0, 15 and 30. The immunized mice were then challenged on day 45 with inoculums of 1 x 103 IE, consisting mainly of ring stage of the plasmodial parasite. The course of infection, leukocyte counts and splenic parameters was observed post challenge. The protection was assessed in terms of (i) duration of pre-patent period, (ii) % peak parasitemia, (iii) duration of the patent period, and outcome of challenge in terms of mortality (% survival) [20].
Preparation of the immunized mouse serumBlood from mice (immunized) was collected without anticoagulant in a sterile glass syringe by cardiac puncture, and was transferred to a sterile centrifuge tube that was kept vertical. While transferring the blood from a syringe to a tube, care was taken to avoid any haemolysis. The blood was allowed to clot by allowing the tube to stand at 37°C for not more than 1 h.
After 30 min, the clot was detached from the walls of the tube with the help of a sterile pasteur pipette. The tube was then kept at 4°C for the contraction of the clot. After keeping it overnight, the serum was separated by centrifugation (10,000 g, 10 min, and 4°C). The clear supernatant (serum) was aseptically transferred into a sterile tube. All the sera were stored in sterile conditions at -20°C until use. Similarly normal mouse serum was prepared from normal mice. Serum was thus obtained from immunized mouse is known as HIS [20].
Passive transfer of protection by HIS2 Groups of mice (3/group) were injected with 0.2 ml of HIS/mouse on days -2,–1, 0, +1, +2, +3, +4, +5, +6, and +7 relative to the day of parasite challenge (day 0), i. P. The control group was injected with 0.2 ml normal mouse serum (NMS)/mouse, similarly. All the mice in each group were challenged with 1x103 homologous IE (rings), i.p, on day 0, and assessed for protection as described [20].
SplenectomyDuring the erythrocytic stages of malaria infection, the spleen is the main organ involved in the development of the immune response and in elimination of pRBC [21]. The mice were anaesthetized and then sacrificed humanely by cervical dislocation. The concerned area was wiped clean using isopropyl alcohol and cut open using sterilized pair of sharp scissors. The spleen was excised and its size and weight were determined to show the difference between immunized, normal mice and infected mice. Also dab smear of spleen of immunized, normal and Pyn infected mice were made and compared with each other (Fig. 2).
Fig. 2: Comparison of dab smears of spleen of (A) Infected mice (B) Immunized mice
Statistical analysisValues are expressed as mean ± S. E. M. in percentage was calculated as: 100-[(mean % parasitemia treated/ control) X 100]. For comparison of mean of different groups one way ANOVA and Student’s t- test was used. All the statistical calculations were made on the Sigma Stat 3.5. A value of p < 0.05 was considered significant.
RESULTS
Study of the course of infection of Pyn –MDR strain in mouse model
Pyn-MDR is a highly virulent strain causing 100% fatality in Swiss mice. The course of infection was studied by infecting i. p. in a group of mice (n=5), with inoculums of 1 x 106 IE respectively (Fig. 3). The percent parasitemia rose from day 2 to day 8. Mice became patent on day 2 and displayed a maximum parasitemia of 69.56 ± 2.22% on day +8. All mice succumbed to the fulminating infection by day +9.

Fig. 3: Courses of infection of P. yoelii nigeriensis in Swiss mice, when inoculums sizes of 1 x 106 IE (n = 5) were given i. p. Parasitaemia is expressed as mean ± S. E. M.
ImmunizationThis was a pilot study to determine the immunizing efficacy of the whole antigen vaccine. Five different groups were made – vehicle control, vehicle + saponin (50 μg), vehicle + NEA (50 μg), vehicle + Pyn-SA (50 μg), and vehicle + Pyn-SA (50 μg) + saponin (50 μg). These groups were given the mentioned doses on day 0, 15 and 30. On day 45, all the groups were challenged with inoculums of 1 x 103 IE. All the mice in the vehicle control group perished on day 16, with a mean parasitemia of 81.43 ± 2.75% at the time of death. The parameters observed were, % parasitemia and pre-patent period. The peak parasitemia reached was around 41% in the immunized group on day +11 (Fig. 4 (a), 4(b)). The survival in this group was also significantly increased (Table 1). While all mice in other groups perished, 4 out of 6 mice, survived in the immunized group. The MST of this batch was over 2 months. The mice were now completely immune to the infection and showed no parasitemia in the blood smears.
Table 1: Effect of different doses of vaccine and saponin on immunization
| Days (post infection) | Vehicle control | Vehicle + saponin(50 ug) | Vehicle + NEA (50 ug) | Vehicle + Pyn-SA (50 ug) | Vehicle + Pyn-SA (50 ug) + saponin (50 ug) |
| 3 | 1.3 ± 0.018 | 1.5 ± 0.364 | 0.106 ± 0.001 | 0.25 ± 0.015 | 0 |
| 4 | 3.5 ± 0.09 | 4.5 ± 0.9 | 1.06 ± 0.09 | 2 ± 0.18 | 1.3 ± 0.23 |
| 5 | 6.3 ± 0.7 | 10.77 ± 0.746 | 4.135 ± 0.32 | 4.3 ± 0.22 | 2.24 ± 0.19 |
| 6 | 12.83 ± 1.72 | 17.34 ± 0.944 | 9.401 ± 0.34 | 7.58 ± 0.28 | 4.5 ± 0.4 |
| 7 | 20.85 ± 1.82* | 41.605 ± 0.714 | 18.94 ± 2.13* | 10.42 ± 0.4 | 7.7 ± 0.39 |
| 8 | 40.5 ± 2.1* | 59.8 ± 2.15* | 33.65 ± 2.22* | 16.08 ± 0.26 | 11.42 ± 0.23 |
| 9 | 65 ± 1.2 | 75.08 ± 1.31 | 41.12 ± 1.73* | 25.02 ± 0.47 | 21.175 ± 0.4 |
| 10 | 75.98 ± 1.58 | 81.33 ± 0.73 | 47.38 ± 1.4 | 30.445 ± 0.57 | 32.951 ± 0.36 |
| 11 | 81.43 ± 2.75* | D | 51.165 ± 2.07 | 41.26 ± 2.5* | 41.64 ± 2.33* |
| 12 | D | D | 68.11 ± 2.14* | 45.93 ± 1.41 | 30.008 ± 1.68* |
| 13 | D | D | D | 50.314 ± 3.19** | 28.02 ± 1.019 |
| 14 | D | D | D | 58.34 ± 3.01 | 24.678 ± 0.27 |
| 15 | D | D | D | 69.48 ± 2.73 | 20.114 ± 0.16 |
| 16 | D | D | D | 78.44 ± 2.79* | 18.812 ± 0.15 |
| 17 | D | D | D | D | 15.03 ± 0.37 |
| 18 | D | D | D | D | 13.178 ± 0.36 |
| 19 | D | D | D | D | 10.23 ± 0.11 |
| 20 | D | D | D | D | 7.06 ± 0.15 |
| 21 | D | D | D | D | 5.3 ± 0.23 |
| 22 | D | D | D | D | 4.1 ± 0.11 |
| 23 | D | D | D | D | 2.3 ± 0.025 |
| 24 | D | D | D | D | 1.1 ± 0.013 |
| 25 | D | D | D | D | 0 |
| 26 | D | D | D | D | 0 |

Fig 4: (a) Challenge results of mice vaccinated with saponin as an adjuvant. Mice (6/experimental group; 6/control groups) were vaccinated, s. c. and i. v. by administering/mouse a. DMEM (0.5 ml as vehicle), b. saponin (50 μg), c. NEA (50 μg), d. Pyn-SA (50 μg), e. vaccine (Pyn-SA + saponin; 50 μg each), on days 0, 15 and 30. All the mice in each group were randomly challenged, i. p., with 1x103 IE/mouse on day 45 after first vaccine shot (day 0 in figure). Percent parasitemia was determined daily by microscopic examination of the Wright’s stained thin tail-blood films. The data are mean ± SD, n = number of mice. (b) Comparison of pre-patent periods of different groups of immunization
Passive transfer of immune protection by HISMice, which received 0.2 ml of NMS, became patent on day +5, developed a fulminating infection on day +15 and died on day +16. Whereas mice which received 0.2 ml HIS, became patent on day +6, developed a fulminating infection of 34.5±6.35 on day +16, in which 1 of them, gradually sub-sided by day +17, and resulted in 60% protection. The parameters observed were, % parasitemia and pre-patent period (Fig. 5 (a), 5(b) (Table 2). Isodiagnostic tests, run individually on the surviving mice, on day +28, confirmed the complete elimination of circulating parasites.
Table 2: Passive transfer of immune protection by HIS
| Days (post infection) | Control group | Experimental group |
| 3 | 0 | 0 |
| 4 | 0 | 0 |
| 5 | 0.903 ± 0.038 | 0 |
| 6 | 5.916 ± 0.3 | 0.815 ± 0.001 |
| 7 | 10.5 ± 0.58 | 4.031 ± 0.02 |
| 8 | 16.5 ± 1.9 | 8.42 ± 0.05 |
| 9 | 19.46 ± 2.34* | 12.15 ± 1.45 |
| 10 | 25.6 ± 4.56* | 14.12 ± 2.13 |
| 11 | 35.256 ± 6.78** (n=2) | 16.33 ± 4.14* |
| 12 | 38.16 ± 7.77** | 19.415 ± 4.3* |
| 13 | 12.47 ± 0.32 | 21.11 ± 5.11* |
| 14 | 5.68 ± 0.18 | 25.295 ± 5.9** |
| 15 | 2.2 ± 0.44 (n=0) | 30.15 ± 6.05** |
| 16 | D | 34.5 ± 6.35*** |
| 17 | D | 21.90 ± 3.22 (n=2) |
| 18 | D | 14.2 ± 1.45 |
| 19 | D | 9.7 ± 0.6 |
| 20 | D | 5.5 ± 0.25 |
| 21 | D | 2.81 ± 0.33 |
| 22 | D | 0 |

Fig. 5: (a) Passive transfer of protection against P. yoelii nigeriensis in mice which received HIS - 2 Groups of 3 mice each were injected i. p., with, 0.2 ml of HIS/mouse on days -2,-1, 0, +1,+2, +3,+4, +5,+6, +7,+8 and +9 relative to the day of parasite challenge (day 0). The control group of mice were injected, 0.2 ml/mouse of NMS, similarly (b) Comparison of pre-patent periods of different group during passive transfer of infection.
Determination of Splenic parametersWhen mice are completely immune to infection then there spleen were removed, its size, weight and shape were determined (Fig. 6) (Table 3). There is the clear difference between spleen of immunized, normal and infected mice spleen. As malaria parasite destroys RBCs that are usually removed from circulation by spleen therefore weight of the spleen is expected to be increased in plasmodium infected mice but in case of malaria immunized mice parasitemia was decreased so the size of the spleen comparable to size of normal mice spleen.
Table 3: Splenic parameters of different groups
| Groups | Body weight (g) | Spleen weight (g) | Size (cm) |
| Normal mice | 25.5 ± 2 | 0.118 ± 0.8 | 1.7 |
| Immunized mice | 25 ± 2 | 0.14 ± 0.004 | 1.9 |
| Pyn-MDR infected mice | 22.5 ± 0.5 | 0.2 ± 0.004 | 2.3 |

Fig. 6: Comparison of Spleen size in A) Normal mice, B) Pyn-SA immunized mice and C) Pyn-MDR infected mice
DISCUSSIONIn the present studies, a new rigorous rodent malaria vaccination model has been successfully developed by using Pyn-SA, and saponin as an adjuvant. Because at present apparently no robust rodent malaria vaccination model is available for the evaluation of new potential adjuvants, this model may now be very useful in the evaluation of new potential synthetic and or natural products-derived adjuvants. It is clear that widespread and increasing resistance of malaria parasites to antimalarial drugs, vaccination against malaria is the only cost-effective and implementable strategy to control malaria [22]. Several studies have demonstrated that Ig purified from the sera of immune adults living in endemic regions, and experimentally immunized animals can passively transfer protection against live challenge [23].
Animal studies of malaria vaccination clearly demonstrate the potential for the induction of protective immunity following active immunization using different Plasmodial component e. g. immunization with P. knowlesi Mz can induce immunity which has been found to be superior than the immunity development from natural infection [24]. In this study the host parasites system, Pyn infection in mice has been utilized. Pyn is known to cause a very severe, fulminating infection in mice which invariably results in their death due to heavy infection. In this study rodent malaria vaccination models have been developed using Pyn-SA and saponin as adjuvant, in order to study new dimensions of immune response. The rodent malaria parasites Pyn produces generally self-limiting infection in laboratory mice and this experimental model has been used in a number of recent studied of acquired immunity to malaria [25]. The development of immunity to Pyn has been shown to be T cell dependent and B cell dependent [26]. Passive transfer experiments have shown that a protective humoral factor, presumably antibody, is present in the serum of recovered mice [27] while other work has indicated that antibody independent cell- mediated immune response mechanisms may play a role in the acquisition and maintenance of immunity to Pyn [27]. In the general lethal malaria infections to reinfection caused by Pyn in mice and by P. falciparum in naïve children, it is not clear what constitutes a protective immune response in patients who survive primary infections without any experimental or therapeutic intervention [28]. While a large body of literature exists on the role of acquired immune response in immunity against malaria relatively little is known about the native or early immune mechanisms effective against a potentially lethal primary malaria infection [29]. Furthermore it takes many years for natural immunity to develop, and the immunity is not only species but also stage specific. Although immunity to malaria is complex and not properly understood, a number of different immune effectors’ mechanisms are well described including CD8+ T cells (liver stage) and both antibody and CD4+ T cells to the blood stage [30]. In the recent years the antigen specificity of some of these immunological processes has been defined and selected antigenic targets are now being incorporated into putative vaccines. How these antigens are delivered how their immunogenicity is enhanced and how and with what other antigens they are combined will largely determines the speed at which effective malaria vaccine for humans are developed [31].
CONCLUSION
A 100% lethal host/parasite system would be an ideal system for experimental vaccination studies. Wherein the protection results can be expected to be free-from infection-induced immunity and other host-related factors. Pyn invariably caused a fulminant 100% lethal infection in mice (as seen in the control groups). The protection observed in the vaccinated group of mice can be unambiguously ascribed to vaccine-induced protective immunity only [20]. Therefore, it was concluded that Pyn/Swiss mice model can be very useful for screening of potential new adjuvants/co-adjuvants. The results of this study clearly demonstrate that vaccination of Swiss mice with Pyn total parasite soluble antigen (Pyn-SA) and saponin, following 100% lethal homologous challenge, has often resulted in 60% protection. So far the mechanisms of protective immunity concerned which is not completely understood, it is believed that, both humoral and cellular mechanisms provide immune protection.
ABBREVIATIONS
8 DMEM- Dulbecco’s modified eagle’s medium, HIS- Hyper immune serum, IE- Infected erythrocytes, MDR- Multi drug resistant, NEA-Normal erythrocyte antigen, NL - Non lethal, NMS-Normal mouse serum, NF-kB-Nuclear factor, NK cells- Natural killer cells, pRBC-Parasitized red blood cells, Pyn-P. yoelii nigeriensis, Pyn-SA-P. yoelii nigeriensis soluble antigen, QS-Quillaja saponaria.CONFLICT OF INTEREST
Author declares no conflicts of interest.
REFERENCES